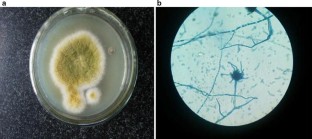

Abstract
We report a 42 year old non-smoker male who presented with progressive exertional dyspnoea, productive cough with streaky hemoptysis and progressive pedal edema. His physical examination, ECG, chest X-ray and 2D-ECHO revealed features suggestive of right heart failure and pulmonary hypertension. On further evaluation for the cause of pulmonary hypertension, his CT pulmonary angiography revealed features of chronic pulmonary thromboembolism with calcified thrombus in the main pulmonary artery along with pulmonary hypertension. Incidentally the CT also revealed a cavity in the right lung with soft tissue within it. A, trans-thoracic needle aspiration of this tissue was suggestive of an aspergilloma. This is a rare case report of co-existence of two uncommon complications of pulmonary embolism-chronic thrombo-embolic pulmonary hypertension and pulmonary Aspergilloma in the same patient.

References
Konstantinides SV, Torbicki A, Agnelli G et al (2014) ESC guidelines on the diagnosis and management of acute pulmonary embolism. Eur Heart J 2014(35):3033–3073
Miniati et al (2006) Survival and restoration of pulmonary perfusion in a long-term follow-up of patients after acute pulmonary embolism. Medicine 85:253–262
Regnard et al (2000) Aspergilloma: a series of 89 surgical cases. Ann Thorac Surg 69:898–903
Passera et al (2012) Pulmonary aspergilloma clinical aspects and surgical treatment outcome. Thorac Surg Clin 22:345–361
Morris TA, Fedullo PF (2010) Pulmonary thromboembolism. In: Murray JF, Nadel JA, Mason RJ et al (eds) Textbook of respiratory medicine, vol 51, 5th edn., SaundersElsevier Inc, Philadelphia, pp 1186–1216
Stein et al (1995) Untreated patients with pulmonary embolism—outcome, clinical, and laboratory assessment. Chest 107:931–935
Gadkowski LB, Stout JE (2008) Cavitary pulmonary disease. Clin Microbiol Rev 21(2):305–333
Author information
Authors and Affiliations
Corresponding author
Ethics declarations
Conflict of interest
None.
Rights and permissions
About this article
Cite this article
Bhartiya, M., Saxena, P., Singh, D. et al. Pulmonary Hypertension and Pulmonary Aspergilloma-Coexistence of Two Rare Sequelae of Pulmonary Embolism. Indian J Hematol Blood Transfus 32 (Suppl 1), 242–245 (2016). https://doi.org/10.1007/s12288-015-0614-2
Received:
Accepted:
Published:
Issue Date:
DOI: https://doi.org/10.1007/s12288-015-0614-2

